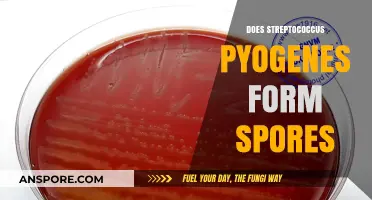
Streptococcus Pyogenes: Understanding Its Sporulation Capabilities and Implications

Tea tree oil, a popular essential oil derived from the leaves of the Melaleuca alternifolia plant, is widely recognized for its potent antimicrobial properties. Its effectiveness against various bacteria, viruses, and fungi has led many to wonder whether it can also combat mold spores, which are notorious for their resilience and ability to thrive in damp environments. Mold spores pose health risks and can damage surfaces, making their eradication a priority for homeowners and health-conscious individuals alike. This raises the question: does tea tree oil possess the capability to kill mold spores, offering a natural and potentially safer alternative to chemical mold removers? Exploring its antifungal properties and application methods can provide valuable insights into its efficacy in mold control.
| Characteristics | Values |
|---|---|
| Effectiveness Against Mold Spores | Tea tree oil is effective in killing mold spores due to its antifungal properties. |
| Active Compound | Terpinen-4-ol is the primary compound responsible for its antifungal activity. |
| Concentration Required | Typically, a 5-10% solution of tea tree oil in water is recommended for mold treatment. |
| Application Method | Can be applied directly to moldy surfaces or diffused in the air to inhibit spore growth. |
| Safety Precautions | Should be used in well-ventilated areas; avoid ingestion and skin contact without dilution. |
| Environmental Impact | Considered a natural, eco-friendly alternative to chemical mold killers. |
| Residual Effect | Provides long-lasting protection against mold recurrence when applied regularly. |
| Scientific Studies | Multiple studies confirm its efficacy against common mold species like Aspergillus and Penicillium. |
| Cost | Generally affordable and widely available in health and home stores. |
| Shelf Life | When stored properly, tea tree oil remains effective for up to 2 years. |
Explore related products
What You'll Learn

Effectiveness of tea tree oil concentration on mold spore elimination
Tea tree oil, derived from the leaves of Melaleuca alternifolia, is renowned for its antifungal properties, making it a popular natural remedy for mold issues. However, its effectiveness in killing mold spores hinges significantly on concentration. Studies indicate that tea tree oil must be used at a concentration of at least 5% to effectively eliminate mold spores on surfaces. Lower concentrations may inhibit mold growth but often fail to eradicate spores entirely. For instance, a 2% solution can reduce mold colonies by up to 70%, but a 5% solution achieves near-complete eradication in controlled environments. This highlights the importance of precise dosing for optimal results.
When applying tea tree oil for mold remediation, dilution ratios are critical. A common recommendation is to mix 1 teaspoon of 100% pure tea tree oil with 1 cup of water for a 5% solution. This mixture can be sprayed directly onto mold-affected areas, allowed to sit for at least 30 minutes, and then wiped clean. For more stubborn mold, increasing the concentration to 10% (2 teaspoons per cup of water) may be necessary, but caution is advised, as higher concentrations can be harsh on certain surfaces like painted walls or fabrics. Always test a small area first to avoid damage.
Comparatively, tea tree oil’s effectiveness against mold spores rivals that of commercial fungicides, but its natural origin makes it a safer alternative for households with children or pets. Unlike bleach, which only removes surface mold and can release harmful fumes, tea tree oil penetrates porous materials to target spores at their source. However, it’s less potent than professional-grade mold removers, making it best suited for small-scale infestations rather than systemic mold problems. Combining tea tree oil with preventive measures, such as reducing humidity levels, enhances its efficacy.
A practical tip for maximizing tea tree oil’s mold-fighting potential is to pair it with other natural antifungals. For example, adding 5–10 drops of tea tree oil to a vinegar-based cleaning solution (1 part vinegar to 3 parts water) creates a synergistic effect, as vinegar’s acidity disrupts mold cell walls, allowing the oil to penetrate more effectively. This combination is particularly useful for bathroom tiles, grout, and shower curtains. Regular application, especially in moisture-prone areas, can prevent mold recurrence and maintain a healthier indoor environment.
In conclusion, the effectiveness of tea tree oil on mold spore elimination is concentration-dependent, with 5% being the threshold for reliable results. While it offers a natural, safe alternative to chemical treatments, its success relies on proper dilution, application technique, and complementary strategies. For those seeking an eco-friendly mold solution, tea tree oil is a viable option, but it’s not a one-size-fits-all remedy. Understanding its limitations and optimizing its use ensures the best outcomes in mold control.
Does Anthrax Form Spores? Understanding the Deadly Bacteria's Survival Mechanism
You may want to see also

Tea tree oil vs. bleach for mold spore eradication
Tea tree oil and bleach are two popular agents for mold remediation, but their mechanisms, applications, and safety profiles differ significantly. Bleach, a chlorine-based solution, works by breaking down mold’s cellular structure through oxidation. It’s effective on non-porous surfaces like tiles or glass but struggles to penetrate porous materials like drywall or wood, where mold roots (hyphae) can survive. Tea tree oil, on the other hand, is a natural fungicide that disrupts mold cell membranes. Studies show it can kill mold spores on contact, even on porous surfaces, due to its ability to penetrate deeper than bleach. However, its efficacy depends on concentration—typically, a 5–10% solution in water is recommended for mold treatment.
Application and Dosage: To use bleach, mix 1 cup of household bleach per gallon of water and apply directly to the moldy area. Let it sit for 15 minutes before scrubbing and rinsing. For tea tree oil, add 20–30 drops (approximately 1 teaspoon) to a spray bottle filled with 2 cups of water. Shake well and spray directly onto the mold, leaving it to air dry. Bleach requires immediate ventilation due to toxic fumes, while tea tree oil is safer for indoor use but should still be applied in a well-ventilated area. Both methods require protective gear, such as gloves and a mask, to avoid skin irritation or inhalation risks.
Safety and Environmental Impact: Bleach is harsh and corrosive, posing risks to skin, eyes, and respiratory health. It also releases volatile organic compounds (VOCs) that contribute to indoor air pollution. Tea tree oil is gentler but can cause allergic reactions in sensitive individuals. It’s biodegradable and eco-friendly, making it a preferred choice for those prioritizing sustainability. However, bleach is more cost-effective for large-scale mold infestations, while tea tree oil is better suited for small, recurring mold issues or preventative maintenance.
Long-Term Efficacy: Bleach may leave behind residue that provides a food source for mold regrowth, especially if not thoroughly rinsed. Tea tree oil, with its residual antimicrobial properties, can inhibit mold recurrence for weeks after application. For example, a study published in the *Journal of Essential Oil Research* found that tea tree oil prevented mold regrowth on treated surfaces for up to 4 weeks, whereas bleach-treated surfaces showed regrowth within 2 weeks. This makes tea tree oil a more sustainable solution for areas prone to moisture, like bathrooms or basements.
Practical Tips: For stubborn mold, combine both methods—use bleach first to remove visible mold, then follow up with tea tree oil to kill lingering spores and prevent recurrence. Always test tea tree oil on a small area first, as it can discolor certain surfaces. For porous materials, consider replacing them if mold penetration is severe, as neither solution can fully eradicate deeply embedded spores. Ultimately, the choice between tea tree oil and bleach depends on the scale of the problem, surface type, and personal preference for natural vs. chemical solutions.
Do Fern Spores Blow in the Wind? Unveiling Nature's Tiny Travelers
You may want to see also

Long-term prevention of mold growth using tea tree oil
Tea tree oil, derived from the leaves of Melaleuca alternifolia, is a potent natural antifungal agent. Its active compound, terpinen-4-ol, disrupts cell membranes of mold spores, effectively killing them on contact. This makes it a promising tool for long-term mold prevention, especially in damp areas like bathrooms, kitchens, and basements. However, its efficacy depends on proper application and maintenance.
To harness tea tree oil’s preventive power, start by diluting 1 teaspoon of 100% pure tea tree oil in 1 cup of water. This 1:20 ratio ensures potency without overwhelming surfaces. Spray the solution directly onto mold-prone areas, such as shower tiles, grout, and under sinks. For persistent problem zones, add 5–10 drops of tea tree oil to a diffuser or cotton balls placed near moisture sources. Reapply weekly to maintain its antifungal barrier, as the oil’s volatility requires regular replenishment.
While tea tree oil is effective, it’s not a standalone solution. Pair its use with environmental controls to address root causes of mold. Reduce humidity levels below 50% using dehumidifiers, ensure proper ventilation in enclosed spaces, and promptly fix leaks. Tea tree oil complements these measures by inhibiting spore germination, but it cannot counteract chronic moisture issues. Think of it as a proactive defense, not a cure for systemic dampness.
For long-term success, integrate tea tree oil into a holistic mold prevention routine. After cleaning moldy surfaces with a vinegar or hydrogen peroxide solution, apply the diluted tea tree oil to create a residual protective layer. Store the oil in a cool, dark place to preserve its potency, and avoid mixing it with other cleaning agents that may reduce its efficacy. With consistent use, tea tree oil becomes a sustainable, chemical-free ally in maintaining mold-free environments.
Are Spores Heat Resistant? Uncovering Their Survival Mechanisms
You may want to see also
Explore related products

Scientific studies on tea tree oil’s antifungal properties
Tea tree oil, derived from the leaves of Melaleuca alternifolia, has long been touted for its antimicrobial properties. Scientific studies have specifically examined its efficacy against mold spores, shedding light on its potential as a natural antifungal agent. Research indicates that tea tree oil contains terpinen-4-ol, a compound responsible for its antifungal activity. A study published in the *Journal of Applied Microbiology* found that a 0.25% concentration of tea tree oil effectively inhibited the growth of Aspergillus niger, a common mold species. This suggests that even low concentrations can be potent against mold spores, making it a viable option for household use.
To harness tea tree oil’s antifungal properties, dilution is key. For surface cleaning, mix 1 teaspoon of tea tree oil with 1 cup of water in a spray bottle. Apply directly to mold-prone areas like bathrooms or kitchens, let it sit for 10–15 minutes, then wipe clean. For persistent mold, increase the concentration to 1–2 teaspoons per cup of water, but exercise caution, as higher concentrations can irritate skin or damage certain surfaces. Always test on a small area first. This method is particularly useful for those seeking non-toxic alternatives to chemical cleaners.
Comparative studies have highlighted tea tree oil’s advantages over synthetic antifungals. A 2018 study in *Mycopathologia* compared tea tree oil to conventional agents like benzalkonium chloride and found it equally effective against various mold species, with the added benefit of being biodegradable and less harmful to humans and pets. However, it’s important to note that tea tree oil may not penetrate porous materials like drywall as effectively as chemical treatments, limiting its use in severe infestations. For best results, combine it with preventive measures like reducing humidity levels.
Despite its efficacy, tea tree oil is not a one-size-fits-all solution. Its effectiveness can vary based on mold species, environmental conditions, and application method. For instance, a study in *Letters in Applied Microbiology* observed that tea tree oil’s antifungal activity decreased in high-moisture environments, emphasizing the need to address underlying moisture issues. Additionally, while safe for most adults, tea tree oil should be kept out of reach of children and pets, as ingestion can be toxic. Always store it in a cool, dark place to preserve its potency.
In conclusion, scientific studies affirm tea tree oil’s antifungal properties, particularly against mold spores, thanks to its active compound terpinen-4-ol. Practical applications, such as diluted sprays, offer a natural and effective alternative to chemical cleaners. However, its limitations—such as reduced efficacy in high-moisture areas and potential risks if misused—underscore the importance of informed application. By combining tea tree oil with preventive strategies, individuals can effectively manage mold growth while minimizing environmental impact.
Did David Create the Spores? Unraveling the Mystery Behind Their Origin
You may want to see also

Safe application methods of tea tree oil for mold removal
Tea tree oil, a potent essential oil derived from the leaves of the Australian Melaleuca alternifolia plant, has been widely recognized for its antifungal properties, making it a popular natural remedy for mold removal. Its effectiveness lies in its ability to penetrate mold spores and disrupt their cell structure, ultimately leading to their demise. However, harnessing this power requires careful application to ensure both efficacy and safety.
Dilution is Key: Undiluted tea tree oil is highly concentrated and can be harsh on surfaces and skin. For mold removal, a safe and effective solution can be prepared by mixing 1 teaspoon (approximately 5 ml) of tea tree oil with 1 cup (240 ml) of water. This dilution ratio ensures the oil's antifungal properties are retained while minimizing potential damage to surfaces or irritation to skin and respiratory systems.
Application Techniques: The method of application depends on the surface and extent of mold growth. For small, localized areas, a spray bottle can be used to apply the diluted solution directly onto the mold. Allow it to sit for at least 30 minutes to an hour, giving the oil ample time to penetrate and kill the spores. For larger areas or porous surfaces like wood, a cloth or sponge can be soaked in the solution and gently wiped or dabbed onto the affected area. This method ensures deeper penetration and more thorough coverage.
Ventilation and Protective Gear: When applying tea tree oil, especially in enclosed spaces, proper ventilation is crucial. Open windows and use fans to ensure a steady flow of fresh air. Wearing protective gear, such as gloves and a mask, is also recommended to prevent skin contact and inhalation of the oil, which can cause irritation or allergic reactions in some individuals.
Post-Application Care: After the oil has had time to work, the area should be thoroughly cleaned to remove dead mold spores and any residual oil. For non-porous surfaces, a simple wipe down with a damp cloth may suffice. Porous materials, however, may require more thorough cleaning or even replacement if the mold has penetrated deeply. It's essential to dry the area completely to prevent future mold growth, as tea tree oil's effectiveness diminishes in the presence of moisture.
In the context of mold removal, tea tree oil offers a natural, effective solution, but its application must be approached with care. By following these safe application methods, individuals can harness the oil's antifungal power while minimizing risks, ensuring a healthier environment free from mold and its associated health hazards. This approach not only addresses the immediate problem but also contributes to long-term prevention, making it a valuable tool in the fight against mold.
Are Mold Spores VOCs? Unraveling the Indoor Air Quality Debate
You may want to see also
Frequently asked questions
Yes, tea tree oil is known to be effective in killing mold spores due to its antifungal and antimicrobial properties. It can inhibit mold growth and eliminate existing spores when applied correctly.
Mix 1 teaspoon of tea tree oil with 1 cup of water in a spray bottle. Apply the solution directly to moldy surfaces, let it sit for at least an hour, then wipe clean. Repeat as needed for stubborn mold.
While tea tree oil can kill mold spores, it is not a permanent solution if the underlying moisture issue persists. Address the source of moisture to prevent mold from returning after treatment.